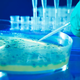

V naselju Suhadole v občini Komenda so v ponedeljek zvečer občani opazili onesnaženo reko Pšato in poginule ribe. Gasilci in mobilni ekološki laboratorij ELME so ob pregledu reke izvor onesnaženja …
Dnevnik · 3L

V naselju Suhadole pri Komendi so krajane v ponedeljek presenetili umazana reka Pšata, na njenem površju pa plavajoče mrtve ribe. Na teren so se takoj odpravili okoliški gasilci ter mobilna …
24ur · 3L

V naselju Suhadole v občini Komenda so v ponedeljek zvečer občani opazili onesnaženo reko Pšato in poginule ribe. Gasilci PGD Kamnik, Moste, Mengeš in mobilni ekološki laboratorij ELME so ob …
24ur · 3L

V Suhadolah pri Komenda so v ponedeljek zvečer nekaj pred 20. uro občani opazili onesnaženo reko Pšato in poginule ribe. Gasilci PGD Kamnik, Moste, Mengeš in mobilni ekološki laboratorij ELME …
RTV Slovenija · 3L
Napaka zasilno popravljena. V naselju Suhadole v občini Komenda so v ponedeljek zvečer občani opazili onesnaženo reko Pšato in poginule ribe. Gasilci PGD Kamnik, Moste, Mengeš in mobilni ekološki laboratorij …
Žurnal24 · 3L

Iz reke so odstranili poginule ribe, gasilci pa so našli izvor onesnaženja. V naselju Suhadole v občini Komenda so v ponedeljek zvečer občani opazili onesnaženo reko Pšato in poginule ribe …
Metropolitan.si · 3L

V naselju Suhadole v občini Komenda so v ponedeljek zvečer občani opazili onesnaženo reko Pšato in poginule ribe. Gasilci PGD Kamnik, Moste, Mengeš in mobilni ekološki laboratorij ELME so ob …
Hudo.com · 3L

V naselju Suhadole v občini Komenda so v ponedeljek zvečer občani opazili onesnaženo reko Pšato in poginule ribe. Gasilci PGD Kamnik, Moste, Mengeš in mobilni ekološki laboratorij ELME so ob …
Siol.net · 3L

V naselju Suhadole v občini Komenda so v ponedeljek zvečer občani opazili onesnaženo reko Pšato in poginule ribe. Gasilci PGD Kamnik, Moste, Mengeš in mobilni ekološki laboratorij ELME so ob …
24ur · 3L

Kriva je bila mehanska napaka na kanalizacijskem sistemu. Včeraj malo pred 20. uro so prebivalci naselja Suhadole v občini Komenda v reki Pšati opazili onesnaženje in poginule ribe. Na kraj …
Svet24 · 3L